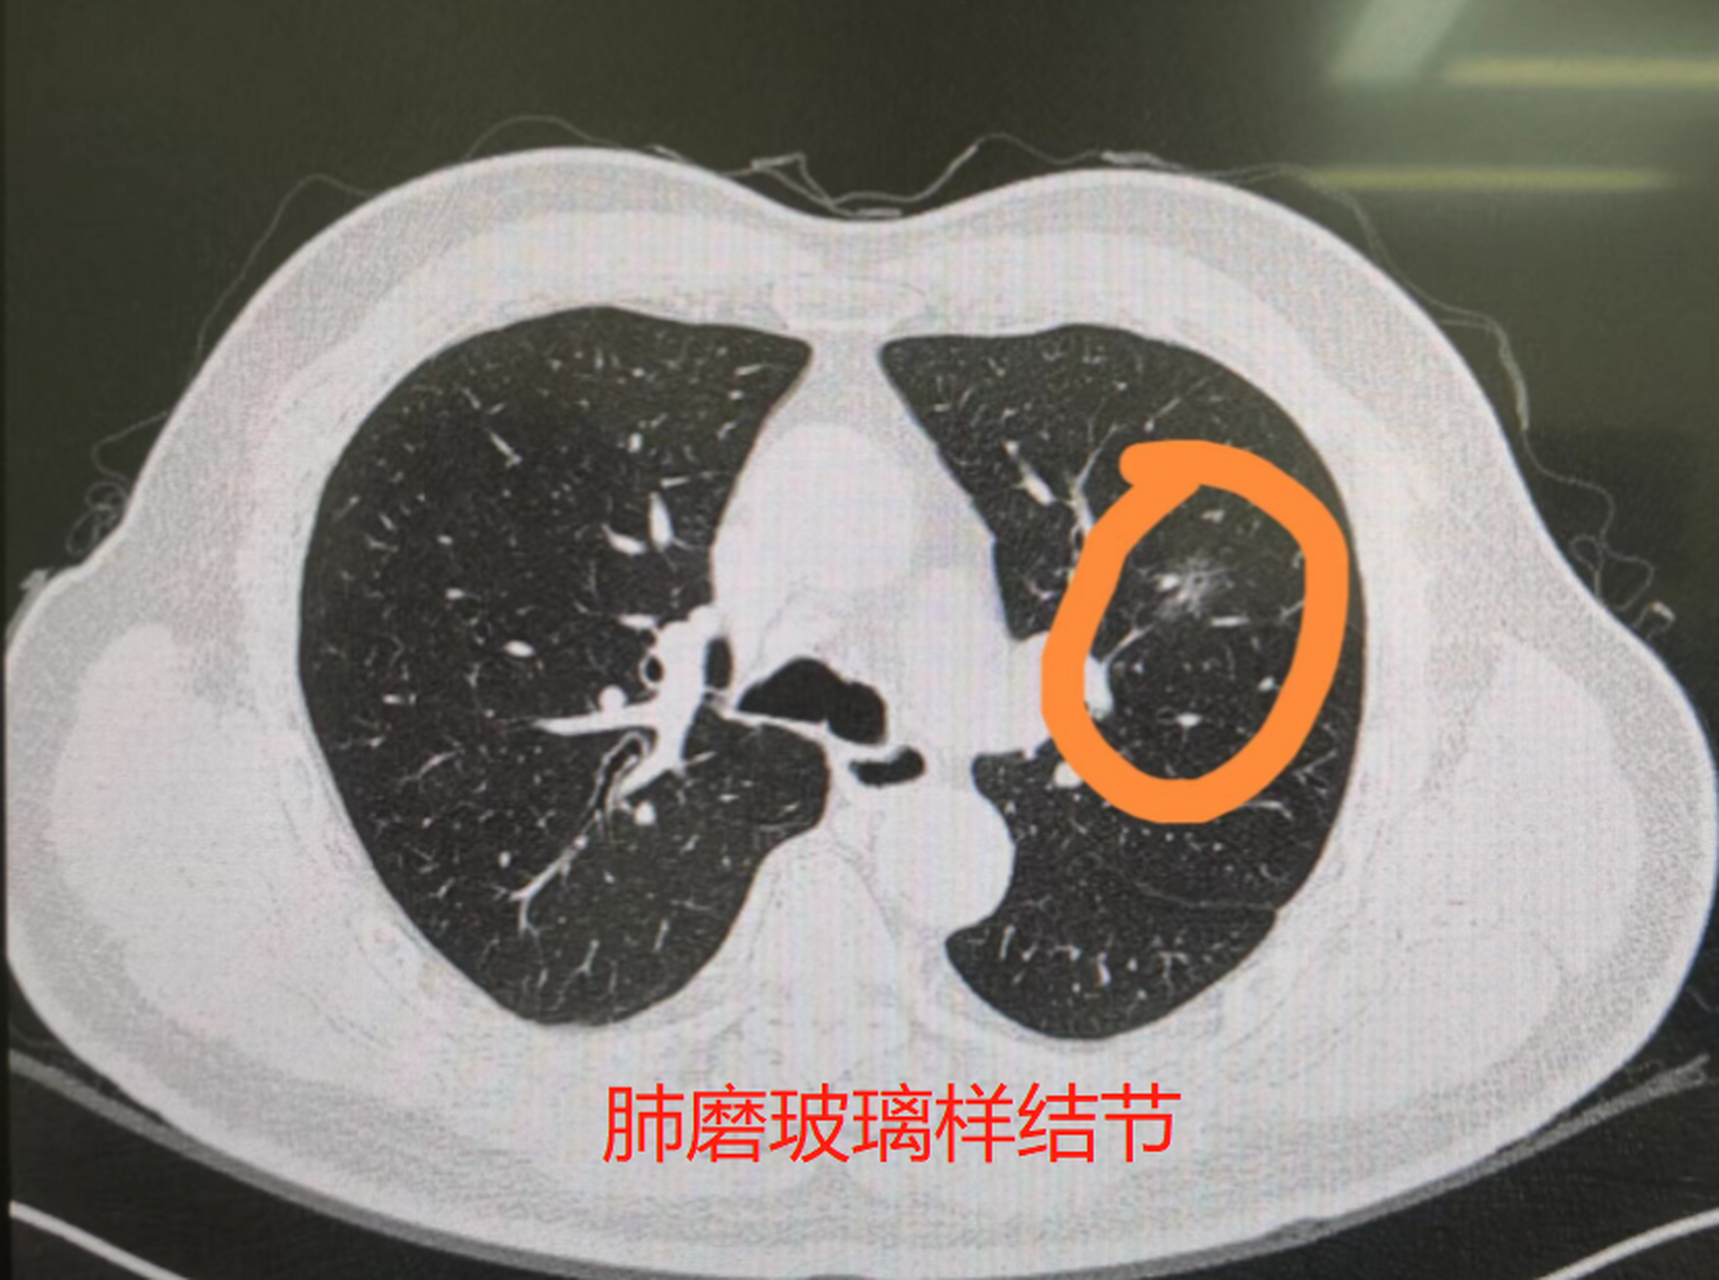
这些这些磨玻璃结节,一般是根据它的密度和均匀程度来区分的,一般磨

纯磨玻璃结节

左图:纯磨玻璃结节右图:部分实性的磨玻璃结节其实大家比较担心的是
图片尺寸1080x599
这些这些磨玻璃结节,一般是根据它的密度和均匀程度来区分的,一般磨
图片尺寸1719x1280
肺磨玻璃结节之十问十答
图片尺寸3968x2976
肺部磨玻璃结节,磨玻璃肺癌_肺部结节_肺部结节缓解方法 - 好大夫在线
图片尺寸1706x1280
多发磨玻璃结节,一网打尽#肺结节 #肺结节三维重建 #磨玻璃 - 抖音
图片尺寸1440x1920
右上纯磨玻璃结节,病理为腺癌
图片尺寸567x641
磨玻璃肺结节vs实性肺结节谁更可怕
图片尺寸640x480
那些年被随访过的肺磨玻璃结节
图片尺寸752x455
肺磨玻璃结节之十问十答
图片尺寸3968x2976
性结节和亚实性结节,亚实性结节又分为纯磨玻璃结节和混合磨玻璃结节
图片尺寸828x1104
磨玻璃结节中有空泡会是恶性的吗
图片尺寸1080x1440
肿瘤性磨玻璃结节随访增大就需要手术?_肺部结节 - 好大夫在线
图片尺寸3456x4608
什么是肺部磨玻璃结节?_肺癌_检查_介绍 - 好大夫在线
图片尺寸1804x2404
磨玻璃结节一般分为纯磨玻璃结节和混合型磨玻璃结节.
图片尺寸375x264
肺部磨玻璃结节groundglassnoduleggn的再认识
图片尺寸640x550
肺磨玻璃结节典型病例分享患者需要上传什么样的照片
图片尺寸4033x3024
磨玻璃结节密度淡好还是深好
图片尺寸640x360
一例肺磨玻璃结节
图片尺寸640x854
肺磨玻璃结节之十问十答
图片尺寸640x480
混合磨玻璃结节,伴有胸膜牵拉——肺腺癌
图片尺寸1440x1408